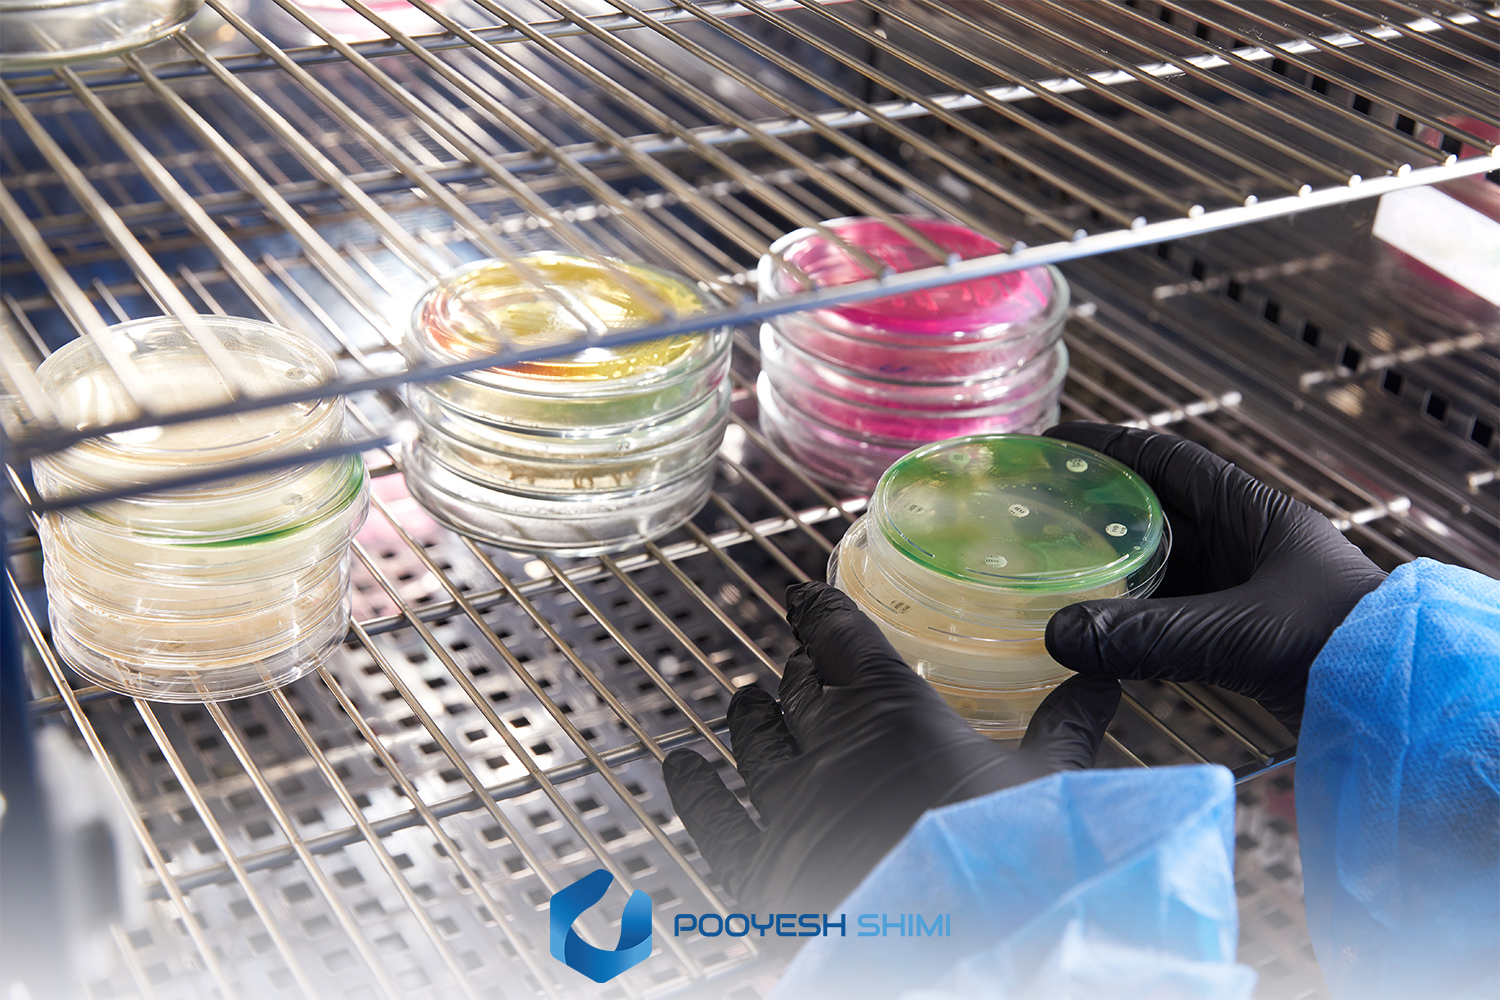

راهنمای جامع کشت میکروبی در انکوباتور آزمایشگاهی
کشت میکروبی به فرآیند فراهم کردن شرایط کنترل شده برای رشد میکروارگانیسم ها (مانند باکتری ها، قارچ ها، مخمرها و حتی جلبک های میکروسکوپی) گفته می شود. این فرآیند نه تنها برای شناسایی عوامل بیماری زا اهمیت دارد، بلکه ابزاری کلیدی برای تولید صنعتی مواد زیستی و تحقیقات پایه نیز به شمار می آید.
چرا کشت میکروبی مهم است؟
- شناخت ویژگی های فیزیولوژیک و رفتاری میکروب ها: از جمله سرعت رشد، نیازهای تغذیه ای، تحمل به شرایط محیطی (مثل اسیدیته یا دما)
- بررسی حساسیت دارویی: در پزشکی، تعیین مقاومت یا حساسیت میکروب ها به آنتیبیوتیک ها فقط با انجام کشت امکان پذیر است.
- تولید ترکیبات ارزشمند: بسیاری از متابولیت های ثانویه مانند آنزیم ها، اسیدهای آلی، ویتامین ها و حتی آنتیبیوتیک ها از طریق کشت میکروبی در مقیاس صنعتی به دست می آیند.
- شناسایی و کنترل آلودگی ها: در صنایع غذایی و داروسازی، وجود حتی مقدار اندک آلودگی میکروبی می تواند سلامت مصرفکننده و اعتبار برند را به خطر بیندازد.
کاربردهای گسترده کشت میکروبی
1. پزشکی و تشخیص آزمایشگاهی
کشت نمونه هایی مانند خون، ادرار، ترشحات تنفسی و زخم ها کمک می کند تا نوع باکتری یا قارچ عامل بیماری شناسایی شود. سپس تست های تکمیلی روی کلنی ها انجام شده و بهترین آنتی بیوتیک برای درمان انتخاب می شود.
2. داروسازی و بیوتکنولوژی دارویی
بسیاری از داروها، به ویژه آنتیبیوتیک ها (مثل پنیسیلین) یا واکسن ها، مستقیماً محصول فرآیندهای کشت میکروبی هستند. کشت کنترل شده می تواند بازده تولید را بالا برده و کیفیت محصول را تضمین کند.
3. صنایع غذایی
در تولید ماست، پنیر، نوشیدنی های تخمیری و حتی نان، میکروارگانیسم ها نقش اساسی دارند. همچنین آزمایشگاه های کنترل کیفیت مواد غذایی با کشت نمونه ها، وجود آلودگی هایی مثل سالمونلا یا اشرشیا کلی را بررسی میکنند.
4. بیوتکنولوژی و زیستصنعت
در این حوزه، کشت میکروبی برای تولید آنزیم های صنعتی (مثل آمیلاز)، ویتامین ها، پروتئین های نوترکیب (مانند انسولین انسانی باکتریایی) و سوخت های زیستی (Biofuels) به کار می رود.
اصول ضروری برای یک کشت موفق
برای دستیابی به نتایج دقیق و تکرارپذیر، سه اصل اساسی باید رعایت شود:
1. انتخاب محیط کشت استاندارد
محیط کشت باید تمام نیازهای تغذیه ای میکروب مورد نظر را تأمین کند. استفاده از محصولات باکیفیت مانند محیط کشت میکروبی مرک اهمیت زیادی دارد، زیرا کوچک ترین خطا در ترکیب محیط می تواند کل آزمایش را تحت تأثیر قرار دهد.
2. انکوباتور آزمایشگاهی با شرایط پایدار
حتی اگر بهترین محیط کشت انتخاب شود، بدون دمای ثابت و شرایط محیطی کنترل شده، رشد مناسب رخ نمی دهد. انکوباتور وظیفه دارد دما، رطوبت و در برخی موارد گازهای محیطی را در محدوده بهینه نگه دارد.
3. رعایت تکنیک های استریل و آسپتیک
کوچک ترین آلودگی می تواند منجر به رشد میکروب های مزاحم شود و کل نتیجه آزمایش را مخدوش کند. استفاده از ابزار استریل، کار در هود میکروبی و ضدعفونی مداوم محیط از ضروریات کشت میکروبی است.
انکوباتور آزمایشگاهی و نقش آن
اهمیت انکوباتور
انکوباتور در واقع محیطی کنترل شده و پایدار برای رشد میکروارگانیسم ها ایجاد می کند. درست مثل رحم مادر برای جنین، این دستگاه دمای ثابت، رطوبت کافی و در برخی موارد شرایط گازی مناسب را فراهم میسازد.
بدون انکوباتور، نتایج کشت میکروبی قابل اعتماد نخواهد بود؛ چون میکروب ها موجوداتی حساس اند و حتی نوسان ۲–۳ درجه دما می تواند باعث تغییر سرعت رشد یا توقف کامل آن شود.
کاربردهای اصلی انکوباتور:
- رشد باکتری ها و قارچ ها در شرایط بهینه
- بررسی اثر آنتی بیوتیک ها و داروها بر روی میکروب ها
- نگهداری و ذخیره سازی نمونه ها در دماهای پایین تر
- ایجاد شرایط خاص برای کشت های بی هوازی یا حساس به pH
انواع انکوباتور و کاربردها
1. انکوباتور ساده (Standard Incubator)
- پرکاربردترین نوع برای کارهای روتین میکروبی
- محدوده دمایی: ۲۵ تا ۴۰ درجه سانتی گراد
- استفاده در کشت باکتری های مزوفیل مثل E. coli یا استافیلوکوک ها
2. انکوباتور یخچالی (Refrigerated Incubator)
- قابلیت تنظیم دما تا حدود ۴–۵ درجه
- مناسب برای کشت باکتری های سایکروفیل (سرماپسند) مثل برخی گونه های موجود در آب های سرد
- برای نگهداری طولانی مدت نمونه ها و محیط های آماده
3. انکوباتور CO₂
- با قابلیت کنترل میزان CO₂ (معمولاً ۵٪)
- برای کشت سلول های یوکاریوتی (مانند سلول های انسانی یا حیوانی)
- کنترل pH محیط کشت از طریق بافر بی کربنات
4. انکوباتور بی هوازی (Anaerobic Incubator)
- مجهز به محفظه بدون اکسیژن
- برای رشد باکتری های بی هوازی اجباری مثل Clostridium
- در تحقیقات پزشکی و صنایع غذایی بسیار مهم است.
5. انکوباتور شیکردار (Shaking Incubator)
- مناسب برای کشتهای مایع
- حرکت یکنواخت باعث افزایش اکسیژنرسانی و جلوگیری از تهنشینی سلولها میشود.
- کاربرد در تولید انبوه آنزیمها و پروتئینهای نوترکیب
پارامترهای قابل کنترل در انکوباتور
- دما: مهم ترین عامل رشد میکروب ها. هر گروه میکروبی (مزوفیل، ترموفیل، سایکروفیل) دامنه دمایی مخصوص خود را دارد.
- رطوبت: محیط های آگار در صورت کمبود رطوبت خشک می شوند و رشد کلنی مختل می گردد. بنابراین برخی انکوباتورها دارای سیستم کنترل رطوبت هستند.
- گازها (CO₂ یا O₂): برخی کشت ها نیازمند درصد خاصی از گاز هستند. برای مثال سلول های انسانی به CO₂ نیاز دارند.
- نور: در بیشتر کشت های باکتریایی لازم نیست، اما جلبک ها و باکتری های فتوسنتزی برای رشد به نور نیاز دارند.
محیط های کشت میکروبی
چرا محیط کشت اهمیت دارد؟
محیط کشت حکم «رژیم غذایی» میکروب ها را دارد. اگر ترکیبات کافی (کربن، نیتروژن، ویتامینها و مواد معدنی) در محیط موجود نباشد، رشد یا بسیار کند خواهد بود یا اصلاً اتفاق نمی افتد. کیفیت مواد اولیه محیط کشت نیز اهمیت زیادی دارد. به همین دلیل، در بیشتر آزمایشگاه های معتبر از محیط کشت میکروبی مرک استفاده می شود؛ چون فرمولاسیون دقیق و استانداردی دارد و نتایج را قابل اعتماد می سازد.
انواع محیط کشت
1. محیط های عمومی (General Purpose Media)
- فرمولاسیون ساده برای رشد طیف وسیعی از باکتری ها
مثال: Nutrient Agar, Tryptic Soy Agar
کاربرد: آزمایش های عمومی و آموزش
2. محیط های غنیشده (Enriched Media)
- حاوی مواد مغذی اضافی مانند خون یا سرم
مثال: Blood Agar, Chocolate Agar
کاربرد: رشد میکروب های سخت پسند مثل Neisseria و Haemophilus
3. محیط های انتخابی (Selective Media)
- دارای مواد مهارکننده برای جلوگیری از رشد گروه های غیرهدف
مثال: MacConkey Agar مهار باکتری های گرم مثبت، رشد گرم منفی ها
کاربرد: شناسایی باکتری ها در نمونه های مخلوط
4. محیط های افتراقی (Differential Media)
امکان تشخیص بین گونه ها یا گروه ها بر اساس تغییر رنگ یا واکنش های بیوشیمیایی
مثال: EMB Agar تمایز لاکتوز مثبت ها از لاکتوز منفی ها
کاربرد: بررسی خصوصیات متابولیکی میکروب ها
5. محیط های ویژه (Specialized Media)
- طراحی شده برای مقاصد خاص تحقیقاتی یا تشخیصی
مثال: Löwenstein–Jensen برای مایکوباکتریوم توبرکلوزیس
کاربرد: بیماری های خاص یا مطالعات تخصصی
مراحل عملی کشت میکروبی در انکوباتور
۱. آماده سازی (Preparation)
قبل از شروع کشت، محیط کار و ابزار باید کاملاً آماده شوند. این مرحله به ظاهر ساده است، اما پایهی اصلی یک کشت موفق محسوب می شود.
- ضدعفونی محیط کار: میز کار یا داخل هود میکروبی باید با الکل ۷۰٪ یا محلول های ضدعفونیکننده ی استاندارد تمیز شود. این کار احتمال آلودگی متقاطع را کاهش می دهد.
- پوشیدن تجهیزات حفاظت فردی (PPE): گان، دستکش و ماسک برای حفاظت از فرد و جلوگیری از انتقال آلودگی به نمونه ضروری است.
- استریلسازی ابزار: لوپ ها، پتریدیش ها، لوله ها و پیپت ها باید در اتوکلاو استریل شوند. در برخی موارد، شعله زدن ابزار فلزی (Flaming) پیش از استفاده نیز لازم است.
- آماده سازی محیط کشت: محیط های آگار یا براث مایع از پیش آماده شده و در دمای مناسب نگهداری می شوند. کیفیت محیط بسیار مهم است؛ به همین دلیل توصیه می شود از برندهای معتبر مانند محیط کشت میکروبی مرک استفاده شود.
۲. تلقیح (Inoculation)
تلقیح به معنای واردکردن میکروارگانیسم به محیط کشت است. این مرحله باید کاملاً آسپتیک انجام شود.
ابزار مورد استفاده: لوپ پلاتینی یا کروم نیکلی، پیپت استریل یا سواب
روش های رایج تلقیح:
- کشت خطی (Streak Plate): با کشیدن لوپ روی سطح آگار، کلنی های جدا از هم به دست می آید. این روش برای جداسازی گونه ها استفاده می شود.
- کشت سطحی (Spread Plate): یک حجم مشخص از سوسپانسیون میکروبی روی سطح آگار ریخته و با اسپاتول استریل پخش می شود. برای شمارش کلنی ها کاربرد دارد.
- کشت مایع (Broth Culture): نمونه به محیط مایع منتقل می شود. این روش برای تکثیر انبوه میکروب ها یا آزمایش های بیوشیمیایی کاربرد دارد.
نکته: هنگام کار با لوپ یا سواب، نباید درپوش پتری یا لوله بیش از حد باز بماند تا از آلودگی محیطی جلوگیری شود.
۳. انکوباسیون (Incubation)
پس از تلقیح، نمونه ها باید در شرایط بهینه در انکوباتور قرار داده شوند.
قرار دادن پتری ها: ظروف آگار باید به صورت وارونه در انکوباتور قرار داده شوند تا قطرات میعان روی سطح کلنی ها نچکد.
تنظیم دما:
- باکتری های انسانی (مزوفیلها): حدود ۳۵–۳۷ درجه
- قارچ ها و کپک ها: ۲۵–۳۰ درجه
- ترموفیل ها: ۵۰–۶۰ درجه
مدت زمان: بسته به نوع میکروب و هدف آزمایش بین ۱۲ تا ۷۲ ساعت متغیر است.
شرایط ویژه: در برخی آزمایش ها نیاز به انکوباتور بیهوازی یا CO₂ است.
۴. بررسی رشد (Observation & Analysis)
پس از مدت زمان مشخص، نتایج باید بررسی و ثبت شوند.
- در محیط جامد: کلنی ها بر اساس شکل، رنگ، اندازه، لبه، برجستگی و شفافیت بررسی می شوند.
- در محیط مایع: میزان کدورت، تشکیل رسوب یا لایه سطحی بررسی می شود.
آزمایش های تکمیلی:
- تست های بیوشیمیایی (مانند تست کاتالاز، اکسیداز)
- رنگ آمیزی گرم برای تشخیص اولیه باکتری ها
- روش های مولکولی (PCR، توالییابی ژنها) برای شناسایی دقیق تر
نکات کلیدی و توصیه های کاربردی
- جایگذاری نمونه ها در انکوباتور: ظروف را به شکلی بچینید که جریان هوا بهخوبی برقرار باشد. تراکم بیش از حد نمونه ها باعث رشد نامتوازن می شود.
- برچسب گذاری: روی هر ظرف یا لوله اطلاعاتی شامل نام نمونه، تاریخ، نوع محیط و شرایط کشت نوشته شود. این کار مانع از اشتباه یا گمشدن نمونه ها می شود.
- ایمنی در برابر میکروب های خطرناک: برای پاتوژن های سطح بالا (مثل Mycobacterium tuberculosis) باید از انکوباتورهای ایزوله و هودهای ایمنی زیستی استفاده شود.
- مدیریت زمان: رعایت زمان دقیق انکوباسیون حیاتی است؛ رشد بیش از حد یا کم تر از حد می تواند نتایج را مخدوش کند.
- استفاده از نمونه شاهد (Control): وجود نمونه کنترل مثبت و منفی در هر آزمایش ضروری است تا درستی نتایج بررسی شود.
خطاها و مشکلات رایج
1. آلودگی محیط کشت:
علت: بازماندن طولانی درب پتری، ابزار غیراستریل یا عدم رعایت بهداشت فردی
راهکار: رعایت اصول آسپتیک، استفاده از محیط های آماده و استریل مانند محصولات مرک
2. عدم رشد میکروب:
علت: انتخاب محیط نامناسب یا تنظیم نادرست دما
راهکار: بررسی نیازهای تغذیه ای میکروب و انتخاب محیط اختصاصی
3. رشد بیش از حد قارچ ها در محیط باکتریایی:
علت: آلودگی قارچی یا نبود مهارکننده ها
راهکار: استفاده از محیط های انتخابی باکتریایی
4. نتایج متناقض یا غیرقابل تکرار:
علت: کیفیت پایین محیط کشت یا نوسان در عملکرد انکوباتور
راهکار: استفاده از محیط کشت های استاندارد و کالیبراسیون منظم دستگاه ها
کاربردهای عملی کشت میکروبی
• پزشکی و بالینی:
کشت خون برای تشخیص عفونتهای سیستمیک
کشت ادرار برای تشخیص عفونتهای مجاری ادراری
کشت ترشحات زخم یا تنفسی برای شناسایی عوامل عفونت
• صنایع غذایی:
تشخیص آلودگی های میکروبی در لبنیات، گوشت و آب
بررسی کیفیت محصولات تخمیری (ماست، دوغ، نان)
• بیوتکنولوژی صنعتی:
تولید پروتئین های نوترکیب مانند انسولین یا هورمون رشد
تولید آنزیم های صنعتی (آمیلاز، پروتئاز)
سنتز ترکیبات زیستی ارزشمند مثل اسید لاکتیک و ویتامین ها
• تحقیقات دانشگاهی و علمی:
بررسی مقاومت آنتی بیوتیکی در جمعیت های میکروبی
مطالعه تعامل میکروب ها با محیط یا سلول های انسانی
اهمیت انتخاب برند معتبر در محیط کشت
اگرچه انکوباتور شرایط رشد را فراهم می کند، اما بدون محیط کشت استاندارد، هیچ نتیجه ای قابل اعتماد نخواهد بود.
ویژگی های کلیدی محیط کشت میکروبی مرک:
- فرمولاسیون دقیق: اطمینان از تأمین نیازهای غذایی میکروب ها
- تکرارپذیری: نتایج حاصل در آزمایش های مختلف یکسان باقی می مانند
- تنوع بالا: از محیط های عمومی تا محیط های تخصصی
- اعتبار جهانی: دارای تأییدیه های بینالمللی ISO و GMP
به همین دلیل، بیشتر آزمایشگاه های تحقیقاتی، آموزشی و صنعتی در جهان از محصولات مرک استفاده می کنند.